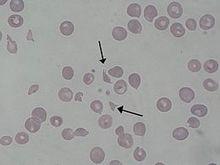
血液病的分類

血液病分類
紅細胞疾病
如各種貧血和紅細胞增多症等。
粒細胞疾病
如白細胞減少和粒細胞缺乏症,中性粒細胞分葉功能不全及類白血病反應等。
單核細胞和巨噬細胞疾病
如反應性組織細胞增多症、惡性組織細胞疾病等。
淋巴細胞和漿細胞疾病
如各類淋巴瘤、急慢性淋巴細胞白血病、多發性骨髓瘤等。
造血幹細胞疾病
如再生障礙性貧血、陣發性睡眠型血紅蛋白尿、骨髓增生異常綜合徵、急性非淋巴細胞白血病以及骨髓增生性疾病(慢性粒細胞白血病、真性紅細胞增多症、原發性血小板增多症以及骨髓纖維化)等。
出血性及血栓性疾病
如過敏性紫癜、血栓性疾病等。
溶血性尿毒綜合徵
溶血性尿毒綜合徵(英語:Hemolytic-uremic syndrome, HUS)是一種由於溶血性貧血(Hemolytic anemia)而引發的急性腎損傷(Acute kidney injury)和血小板數量下降綜合徵。病因不明,發病者多見於但不僅限於嬰幼兒。這一綜合徵最早於1955年定義。2011年,此綜合徵由於Escherichia coli O104:H4細菌引起的食物中毒在德國爆發,並波及歐洲。截止至2011年6月3日已有53人因此死亡。
血液病的分類
血液病的分類新生兒溶血症
新生兒溶血症(HDN, Hemolytic disease of the fetus and newborn)是由於母親和胎兒的血型不同而引起的疾病。若母親體內有對抗胎兒血型的抗體,這些抗體便會經過胎盤,進入胎兒體內,攻擊胎兒的紅血球,引起溶血反應令它有貧血、網狀血球增多或黃疸。嚴重的後果可能致死。
以ABO血型和Rh血型為例:
| 母親 | 父親 | 胎兒 |
| O(OO) | A(AA,AO)或AB(AB) | A(AO) |
| O(OO) | B(BB,BO)或AB(AB) | B(BO) |
| A(AO) | B(BB或BO) | B(BO) |
| B(BO) | A(AA或AO) | A(AO) |
| Rh- | Rh+ | Rh+ |
再生不良性貧血
再生不良性貧血也叫 再生障礙性貧血(簡稱 再障),是指骨髓未能生產足夠或新的細胞來補充血液細胞的情況。一般來說,貧血是指低的紅血球統計,但患有再生不良性貧血的病人會在三種血液細胞種類(紅血球、白血球及血小板)均出現低統計的情況。
病因
現時已知的再生不良性貧血的一個病因是自體免疫性疾病,當中白血球自行攻擊骨髓。
很多的病例都不能清楚判斷病因,但再生不良性貧血有時會與一些物質,如苯、輻射的接觸,或是使用某類藥物,包括氯黴素及苯丁吡唑酮有所關聯,可能會造成骨髓造血細胞的器質性病變。 再生障礙性貧血(簡稱再障)(aplastic anemia)是指由各種原因引起的骨髓造血功能衰竭,造成全血細胞減少的一種疾病。臨床上以紅細胞、粒細胞和血小板減少所致的貧血、感染和出血為特徵。再障在中國大陸地區並非少見,中國大陸流行病學調查資料表明其發病率約為0.74/10萬人口,呈散發性。發病以青中年居多,男性略高於女性,原發性稍多於繼發性。
正鐵血紅蛋白血症
正鐵血紅蛋白血症(Methemoglobinemia),或 高鐵血紅蛋白症、 變性血色蛋白血症、 變性血紅素血症、 變性紅血球血症、 急性變性血紅素症,是指因血液中異常的出現過多不能帶氧的正鐵血紅蛋白(帶Fe離子而不是Fe的血紅蛋白)導致身體出現缺氧變藍症狀。若血液含正鐵血蛋白分量超過一成半,便會出現病徵。
身體因不能製造足夠的正鐵血紅蛋白還原酶,不能把正鐵血紅蛋白還原為帶氧的血紅蛋白,或身體自行生產異常的正鐵血紅蛋白,導致患者紅血球中的血紅蛋白異常,不能帶氧。
